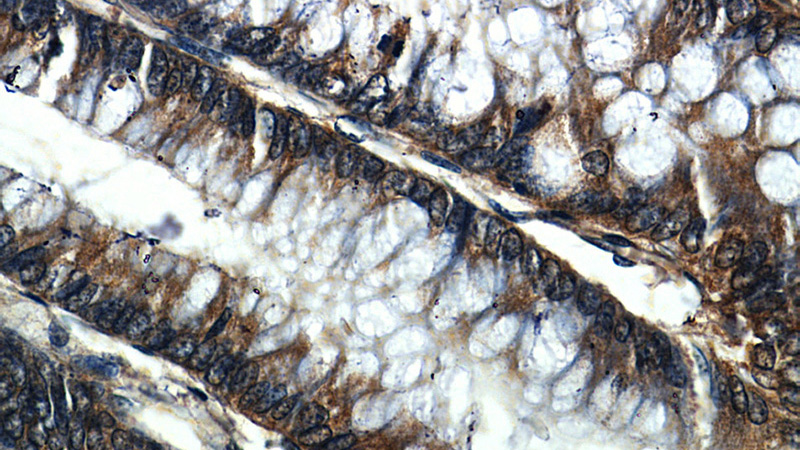
Immunohistochemistry of paraffin-embedded human colon slide using Catalog No:114217(PHB2 Antibody) at dilution of 1:50

-
Product Name
prohibitin 2 antibody
- Documents
-
Description
prohibitin 2 Rabbit Polyclonal antibody. Positive IF detected in HepG2 cells. Positive IHC detected in human colon tissue, human breast cancer tissue. Positive WB detected in HeLa cells, BxPC-3 cells, human brain tissue, K-562 cells, MCF7 cells, mouse heart tissue, mouse stomach tissue. Positive IP detected in HeLa cells. Observed molecular weight by Western-blot: 33 kDa
-
Tested applications
ELISA, IF, IP, IHC, WB
-
Species reactivity
Human,Mouse,Rat; other species not tested.
-
Alternative names
BAP antibody; Bap37 antibody; D prohibitin antibody; p22 antibody; PHB2 antibody; PNAS 141 antibody; prohibitin 2 antibody; REA antibody
-
Isotype
Rabbit IgG
-
Preparation
This antibody was obtained by immunization of prohibitin 2 recombinant protein (Accession Number: NM_001144831). Purification method: Antigen affinity purified.
-
Clonality
Polyclonal
-
Formulation
PBS with 0.1% sodium azide and 50% glycerol pH 7.3.
-
Storage instructions
Store at -20℃. DO NOT ALIQUOT
-
Applications
Recommended Dilution:
WB: 1:500-1:5000
IP: 1:500-1:5000
IHC: 1:20-1:200
IF: 1:20-1:200
-
Validations

HeLa cells were subjected to SDS PAGE followed by western blot with Catalog No:114217(PHB2 antibody) at dilution of 1:1000

Immunohistochemistry of paraffin-embedded human colon slide using Catalog No:114217(PHB2 Antibody) at dilution of 1:50
Immunohistochemistry of paraffin-embedded human colon slide using Catalog No:114217(PHB2 Antibody) at dilution of 1:50

Immunofluorescent analysis of HepG2 cells, using PHB2 antibody Catalog No:114217 at 1:50 dilution and Rhodamine-labeled goat anti-rabbit IgG (red). Blue pseudocolor = DAPI (fluorescent DNA dye).

IP Result of anti-PHB2 (IP:Catalog No:114217, 3ug; Detection:Catalog No:114217 1:1000) with HeLa cells lysate 1840ug.
-
Background
PHB2, also named as BAP, REA, D-prohibitin, BAP37 and Prohibitin-2, belongs to the prohibitin family. It acts as a mediator of transcriptional repression by nuclear hormone receptors via recruitment of histone deacetylases. PHB2 functions as an estrogen receptor (ER)-selective coregulator that potentiates the inhibitory activities of antiestrogens and represses the activity of estrogens. It competes with NCOA1 for modulation of ER transcriptional activity. PHB2 is probably involved in regulating mitochondrial respiration activity and in aging.(PMID: 10359819)
-
References
- Zamilpa R, Lopez EF, Chiao YA. Proteomic analysis identifies in vivo candidate matrix metalloproteinase-9 substrates in the left ventricle post-myocardial infarction. Proteomics. 10(11):2214-23. 2010.
- Liu G, Tian H, Huang YQ. Alterations of mitochondrial protein assembly and jasmonic acid biosynthesis pathway in Honglian (HL)-type cytoplasmic male sterility rice. The Journal of biological chemistry. 287(47):40051-60. 2012.
- Poitelon Y, Bogni S, Matafora V. Spatial mapping of juxtacrine axo-glial interactions identifies novel molecules in peripheral myelination. Nature communications. 6:8303. 2015.
- Li H, Ruan Y, Zhang K. Mic60/Mitofilin determines MICOS assembly essential for mitochondrial dynamics and mtDNA nucleoid organization. Cell death and differentiation. 23(3):380-92. 2016.
Related Products / Services
Please note: All products are "FOR RESEARCH USE ONLY AND ARE NOT INTENDED FOR DIAGNOSTIC OR THERAPEUTIC USE"
